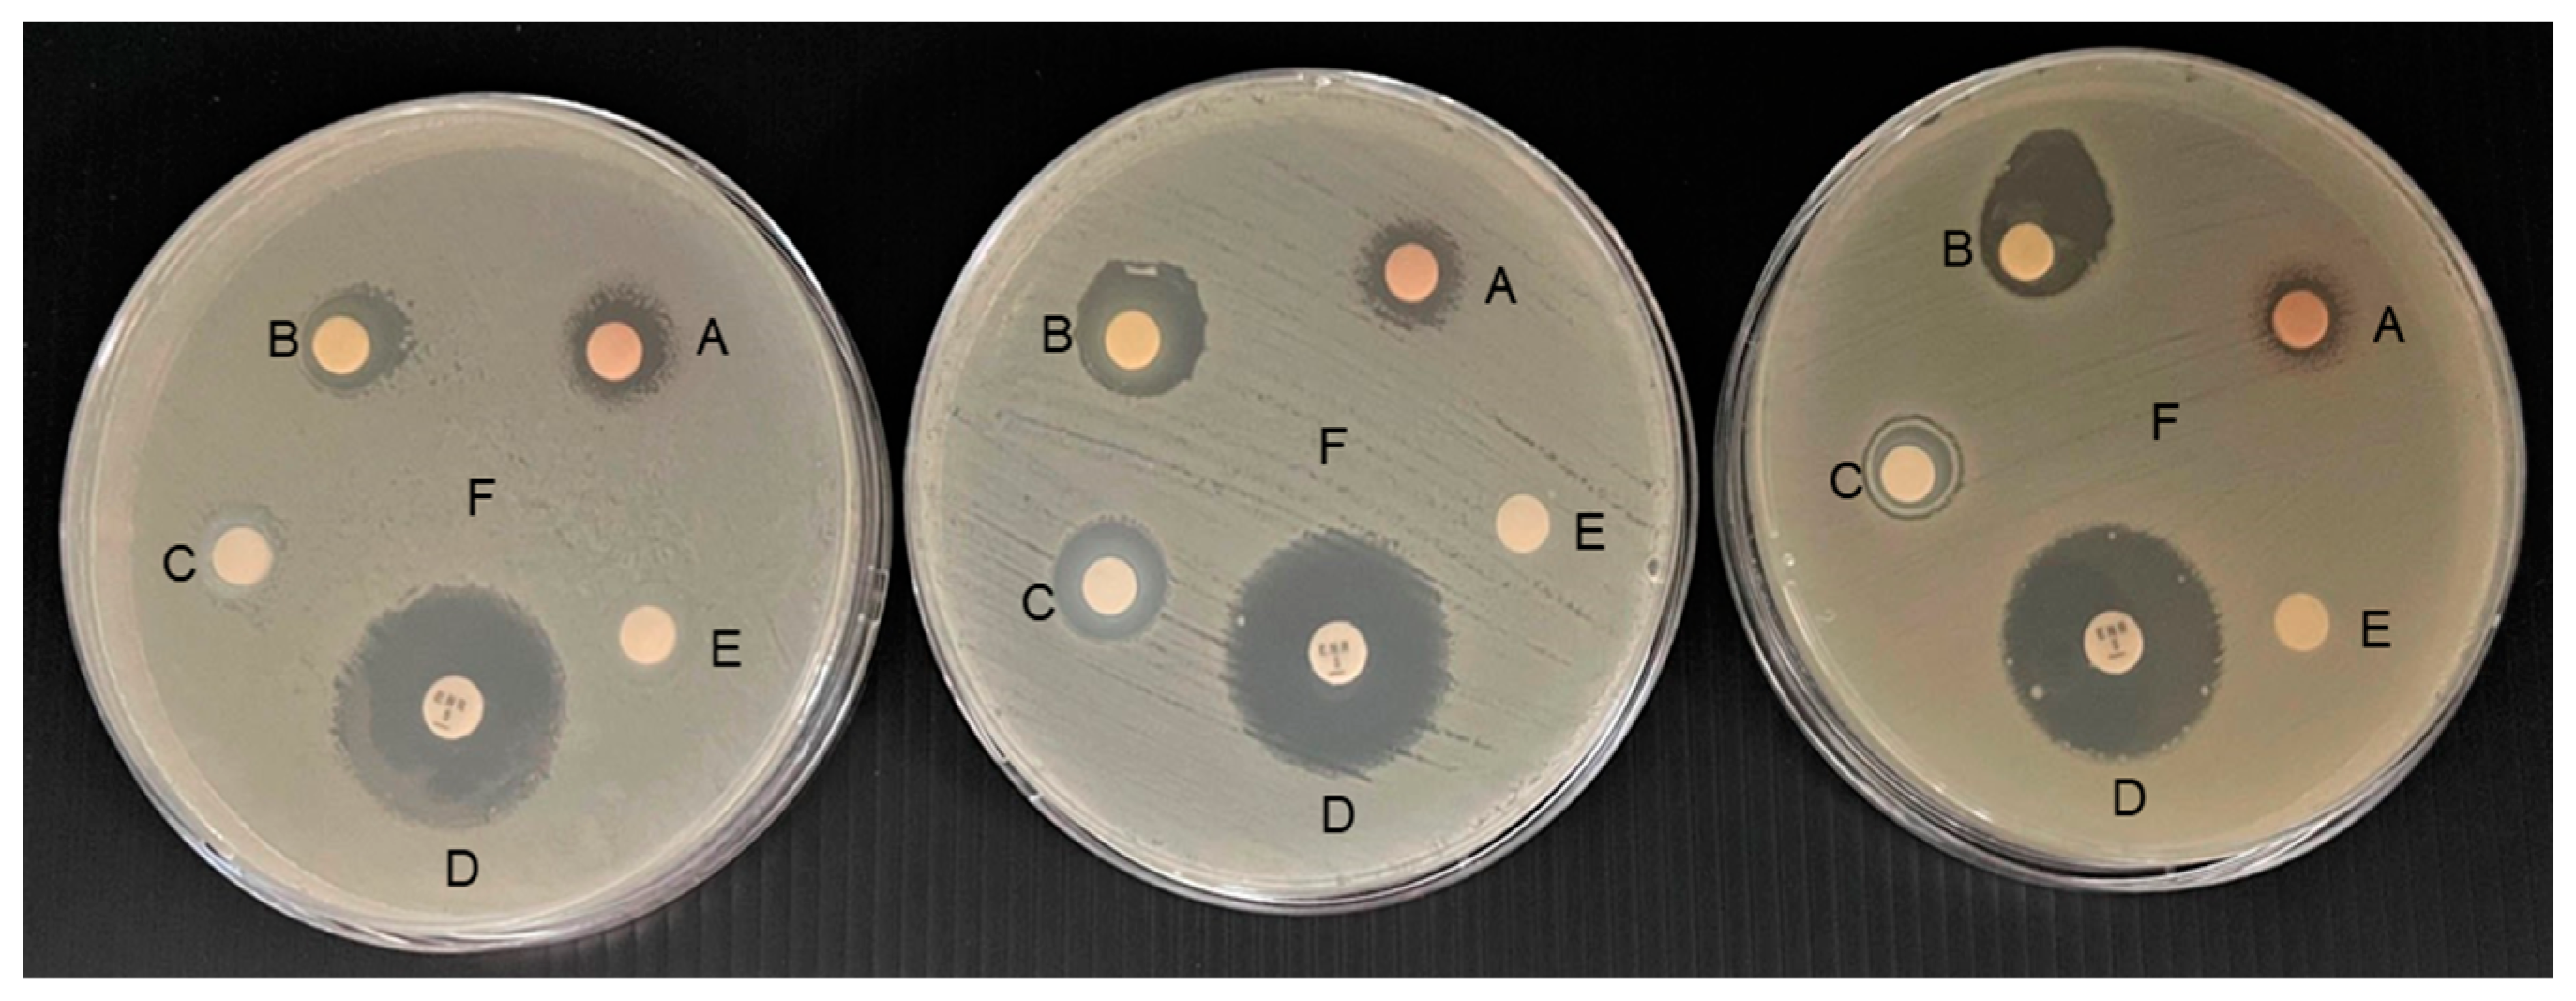

Effects of Mangosteen (Garcinia mangostana) Peel Extract Loaded in Nanoemulsion on Growth Performance, Immune Response, and Disease Resistance of Nile Tilapia (Oreochromis niloticus) against Aeromonas veronii Infection
Abstract
Simple Summary
Abstract
1. Introduction
2. Materials and Methods
2.1. Preparation of Mangosteen Peel Extract Loaded Nanoemulsion
2.2. Characterizations of MSNE
2.3. Antibacterial Activity
2.3.1. Broth Microdilution Assay
2.3.2. Disc Diffusion Assay
2.4. Experimental Fish
2.5. Growth Performance
2.6. Serum Biochemical Analysis
2.7. Immunological Assay
2.8. Challenged Study
2.9. Statistical Analysis
3. Results
3.1. Characterizations of MSNE
3.2. Antibacterial Activity of MSNE
3.3. Growth Performance of MSNE-Supplemented Diet
3.4. Serum Biochemical Analysis of MSNE-Supplemented Diet
3.5. Immune Parameters Analysis of MSNE-Supplemented Diet
3.6. Survival Rates of MSNE-Supplemented Diet
4. Discussion
5. Conclusions
Author Contributions
Funding
Institutional Review Board Statement
Informed Consent Statement
Data Availability Statement
Acknowledgments
Conflicts of Interest
References
- Yamprayoon, J.; Sukhumparnich, K. Thai Aquaculture: Achieving quality and safety through management and sustainability. J. World Aquac. Soc. 2010, 41, 274–280. [Google Scholar] [CrossRef]
- Kamble, M.T.; Yakupitiyage, A.; Salin, K.R.; Chavan, B.R. Effect of Psidium guajava and Phyllanthus acidus leaf extract on immunostimulant response of Nile tilapia against Streptococcus agalactiae infection. Isr. J. Aquac. Bamidgeh 2018, 70, 1–9. [Google Scholar] [CrossRef]
- Ferreira, J.G.; Falconer, L.; Kittiwanich, J.; Ross, L.; Saurel, C.; Wellman, K.; Zhu, C.B.; Suvanachai, P. Analysis of production and environmental effects of Nile tilapia and white shrimp culture in Thailand. Aquaculture 2015, 447, 23–36. [Google Scholar] [CrossRef]
- FAO. The State of World Fisheries and Aquaculture 2022—Towards Blue Transformation; FAO: Rome, Italy, 2022; p. 266. [Google Scholar]
- Do, F. Fisheries Statistics of Thailand 2021; National Inland Fisheries Institute, Department of Fisheries: Bangkok, Thailand, 2021.
- Dong, H.T.; Nguyen, V.V.; Le, H.D.; Sangsuriya, P.; Jitrakorn, S.; Saksmerprome, V.; Senapin, S.; Rodkhum, C. Naturally concurrent infections of bacterial and viral pathogens in disease outbreaks in cultured Nile tilapia (Oreochromis niloticus) farms. Aquaculture 2015, 448, 427–435. [Google Scholar] [CrossRef]
- Dong, H.T.; Techatanakitarnan, C.; Jindakittikul, P.; Thaiprayoon, A.; Taengphu, S.; Charoensapsri, W.; Khunrae, P.; Rattanarojpong, T.; Senapin, S. Aeromonas jandaei and Aeromonas veronii caused disease and mortality in Nile tilapia, Oreochromis niloticus (L.). J. Fish Dis. 2017, 40, 1395–1403. [Google Scholar] [CrossRef]
- Hassan, M.A.; Noureldin, E.A.; Mahmoud, M.A.; Fita, N.A. Molecular identification and epizootiology of Aeromonas veronii infection among farmed Oreochromis niloticus in Eastern Province, KSA. Egypt. J. Aquat. Res. 2017, 43, 161–167. [Google Scholar] [CrossRef]
- Pepi, M.; Focardi, S. Antibiotic-resistant bacteria in aquaculture and climate change: A challenge for health in the mediterranean area. Int. J. Environ. Res. Public Health 2021, 18, 31. [Google Scholar] [CrossRef]
- Raharjo, H.M.; Budiyansah, H.; Mursalim, M.F.; Chokmangmeepisarn, P.; Sakulworakan, R.; Madyod, S.; Sewaka, M.; Sonthi, M.; Debnath, P.P.; Elayaraja, S.; et al. Distribution of Vibrionaceae in farmed Asian sea bass, Lates calcarifer in Thailand and their high prevalence of antimicrobial resistance. J. Fish Dis. 2022, 45, 1355–1371. [Google Scholar] [CrossRef]
- Abd El-Naby, A.S.; El Asely, A.M.; Hussein, M.N.; Fawzy, R.M.; Abdel-Tawwab, M. Stimulatory effects of dietary chia (Salvia hispanica) seeds on performance, antioxidant-immune indices, histopathological architecture, and disease resistance of Nile tilapia. Aquaculture 2023, 563, 738889. [Google Scholar] [CrossRef]
- Abdelghany, M.F.; El-Sawy, H.B.; Abd El-hameed, S.A.; Khames, M.K.; Abdel-Latif, H.M.; Naiel, M.A. Effects of dietary Nannochloropsis oculata on growth performance, serum biochemical parameters, immune responses, and resistance against Aeromonas veronii challenge in Nile tilapia (Oreochromis niloticus). Fish Shellfish Immunol. 2020, 107, 277–288. [Google Scholar] [CrossRef]
- Kamble, M.T.; Chavan, B.R.; Ataguba, G.; Azpeitia, T.; Medhe, S.; Jain, S.; Jadhav, R. Application of Moringa oleifera for development of sustainable and biosecure aquaculture. Aquac. Indones. 2015, 15, 64–73. [Google Scholar] [CrossRef]
- Trullàs, C.; Sewaka, M.; Rodkhum, C.; Chansue, N.; Boonanuntanasarn, S.; Kamble, M.T.; Pirarat, N. Effects of jerusalem artichoke (Helianthus tuberosus) as a prebiotic supplement in the diet of red tilapia (Oreochromis spp.). Animals 2022, 12, 2882. [Google Scholar] [CrossRef]
- Sewaka, M.; Trullas, C.; Chotiko, A.; Rodkhum, C.; Chansue, N.; Boonanuntanasarn, S.; Pirarat, N. Efficacy of synbiotic Jerusalem artichoke and Lactobacillus rhamnosus GG-supplemented diets on growth performance, serum biochemical parameters, intestinal morphology, immune parameters and protection against Aeromonas veronii in juvenile red tilapia (Oreochromis spp.). Fish Shellfish Immunol. 2019, 86, 260–268. [Google Scholar]
- Suttirak, W.; Manurakchinakorn, S. In vitro antioxidant properties of mangosteen peel extract. J. Food Sci. Technol. 2014, 51, 3546–3558. [Google Scholar] [CrossRef]
- Aizat, W.M.; Ahmad-Hashim, F.H.; Jaafar, S.N.S. Valorization of mangosteen, “The Queen of Fruits”, and new advances in postharvest and in food and engineering applications: A review. J. Adv. Res. 2019, 20, 61–70. [Google Scholar] [CrossRef]
- Ansori, A.N.M.; Fadholly, A.; Hayaza, S.; Susilo, R.J.K.; Inayatillah, B.; Winarni, D.; Husen, S.A. A review on medicinal properties of mangosteen (Garcinia mangostana L.). Res. J. Pharm. Technol. 2020, 13, 974–982. [Google Scholar] [CrossRef]
- Meepagala, K.M.; Schrader, K.K. Antibacterial activity of constituents from mangosteen Garcinia mangostana fruit pericarp against several channel catfish pathogens. J. Aquat. Anim. Health 2018, 30, 179–184. [Google Scholar] [CrossRef]
- Lili, W.; Gumilar, R.; Nurhayati, A.; Rosidah, R. Effectivity of solution mangosteen rind (Garciana mangostana) as medicine for black tilapia juvenile (Oreochromis niloticus Bleeker) when infected by Aeromonas hydrophila. World Sci. News 2019, 133, 56–70. [Google Scholar]
- Destiani, A.; Nur, I.; Muskita, W.; Kurnia, A. Effect of diet supplemented with rind powdered of mangosteen fruit (Garcinia mangostana) on haematological profile of clown anemonefish (Amphiprion percula). Res. J. Med. Plant 2019, 13, 46–52. [Google Scholar]
- Soosean, C.; Marimuthu, K.; Sudhakaran, S.; Xavier, R. Effects of mangosteen (Garcinia mangostana L.) extracts as a feed additive on growth and haematological parameters of African catfish (Clarias gariepinus) fingerlings. Eur. Rev. Med. Pharmacol. Sci. 2010, 14, 605–611. [Google Scholar]
- Hill, E.K.; Li, J. Current and future prospects for nanotechnology in animal production. J. Anim. Sci. Biotechnol. 2017, 8, 26. [Google Scholar] [CrossRef] [PubMed]
- Nair, M.; Jayant, R.D.; Kaushik, A.; Sagar, V. Getting into the brain: Potential of nanotechnology in the management of NeuroAIDS. Adv. Drug Deliv. Rev. 2016, 103, 202–217. [Google Scholar] [CrossRef] [PubMed]
- Yostawonkul, J.; Surassmo, S.; Iempridee, T.; Pimtong, W.; Suktham, K.; Sajomsang, W.; Gonil, P.; Ruktanonchai, U.R. Surface modification of nanostructure lipid carrier (NLC) by oleoyl-quaternized-chitosan as a mucoadhesive nanocarrier. Colloids Surf. B Biointerfaces 2017, 149, 301–311. [Google Scholar] [CrossRef] [PubMed]
- Calligaris, S.; Plazzotta, S.; Bot, F.; Grasselli, S.; Malchiodi, A.; Anese, M. Nanoemulsion preparation by combining high pressure homogenization and high power ultrasound at low energy densities. Food Res. Int. 2016, 83, 25–30. [Google Scholar] [CrossRef]
- Yoshimura, M.; Ninomiya, K.; Tagashira, Y.; Maejima, K.; Yoshida, T.; Amakura, Y. Polyphenolic constituents of the pericarp of mangosteen (Garcinia mangostana L.). J. Agric. Food Chem. 2015, 63, 7670–7674. [Google Scholar] [CrossRef]
- Kusmayadi, A.; Adriani, L.; Abun, A.; Muchtaridi, M.; Tanuwiria, U.H. The effect of solvents and extraction time on total xanthone and antioxidant yields of mangosteen peel (Garcinia mangostana L.) extract. Drug Invent. Today 2018, 10, 2572–2576. [Google Scholar]
- Kamble, M.T.; Rudtanatip, T.; Soowannayan, C.; Nambunruang, B.; Medhe, S.V.; Wongprasert, K. Depolymerized fractions of sulfated galactans extracted from Gracilaria fisheri and their antibacterial activity against Vibrio parahaemolyticus and Vibrio harveyi. Mar. Drugs 2022, 20, 469. [Google Scholar] [CrossRef]
- Kamble, M.T.; Gallardo, W.; Yakupitiyage, A.; Chavan, B.R.; Rusydi, R.; Rahma, A. Antimicrobial activity of bioactive herbal extracts against Streptococcus agalactiae biotype 2. Int. J. Basic Appl. Biol. 2014, 2, 152–155. [Google Scholar]
- Al Laham, S.A.; Al Fadel, F.M. Antibacterial activity of various plants extracts against antibiotic-resistant Aeromonas hydrophila. Jundishapur J. Microbiol. 2014, 7, e11370. [Google Scholar] [CrossRef]
- Balouiri, M.; Sadiki, M.; Ibnsouda, S.K. Methods for in vitro evaluating antimicrobial activity: A review. J. Pharm. Anal. 2016, 6, 71–79. [Google Scholar] [CrossRef]
- Pirarat, N.; Pinpimai, K.; Chankow, K.; Malila, K.; Chansue, N.; Niyomtham, W.; Rodkhum, C. In vitro efficacy of human-derived probiotic, Lactobacillus rhamnosus against pathogenic bacteria in fish and frogs. Thai J. Vet. Med. 2015, 39, 305–310. [Google Scholar]
- Mane, A.M.; Dube, K.; Varghese, T.; Chavan, B.R.; Kamble, M.T. Effects of stocking density on growth performance, survival and production of Catla catla and Labeo rohita during nursery rearing in cages. Proc. Natl. Acad. Sci. India Sect. B Biol. Sci. 2019, 89, 275–281. [Google Scholar] [CrossRef]
- Siwicki, A.K.; Anderson, D.P.; Rumsey, G.L. Dietary intake of immunostimulants by rainbow trout affects non-specific immunity and protection against furunculosis. Vet. Immunol. Immunopathol. 1994, 41, 125–139. [Google Scholar] [CrossRef]
- Sunyer, J.O.; Tort, L. Natural hemolytic and bactericidal activities of sea bream Sparus aurata serum are effected by the alternative complement pathway. Vet. Immunol. Immunopathol. 1995, 45, 333–345. [Google Scholar] [CrossRef]
- Pitaksong, T.; Kupittayanant, P.; Boonanuntanasarn, S. The effects of vitamins C and E on the growth, tissue accumulation and prophylactic response to thermal and acidic stress of hybrid catfish. Aquac. Nutr. 2013, 19, 148–162. [Google Scholar] [CrossRef]
- Fajardo, C.; Martinez-Rodriguez, G.; Blasco, J.; Mancera, J.M.; Thomas, B.; De Donato, M. Nanotechnology in aquaculture: Applications, perspectives and regulatory challenges. Aquac. Fish. 2022, 7, 185–200. [Google Scholar] [CrossRef]
- Shah, B.R.; Mraz, J. Advances in nanotechnology for sustainable aquaculture and fisheries. Rev. Aquac. 2020, 12, 925–942. [Google Scholar] [CrossRef]
- Aboofazeli, R. Nanometric-scaled emulsions (nanoemulsions). Iran. J. Pharm. Res. 2010, 9, 325. [Google Scholar]
- Mulia, K.; Putri, G.A.; Krisanti, E. Encapsulation of mangosteen extract in virgin coconut oil based nanoemulsions: Preparation and characterization for topical formulation. In Materials Science Forum; Trans Tech Publications Ltd.: Bali, Indonesia, 2018; Volume 929, pp. 234–242. [Google Scholar]
- Gheorghe, I.; Saviuc, C.; Ciubuca, B.; Lazar, V.; Chifiriuc, M.C. Nanodrug delivery. In Nanomaterials for Drug Delivery and Therapy; Grumezescu, A.M., Ed.; William Andrew Publishing: Norwich, NY, USA, 2019; pp. 225–244. [Google Scholar]
- Sitti, R.H.S.; Sugita, P.; Ambarsari, L.; Rahayu, D.U.C. Antibacterial mangosteen (Garcinia mangostana Linn.) peel extract encapsulated in Chitosan. J. Phys. Conf. Ser. 2018, 1116, 042037. [Google Scholar] [CrossRef]
- Li, P.; Yang, Z.; Tang, B.; Zhang, Q.; Chen, Z.; Zhang, J.; Wei, J.; Sun, L.; Yan, J. Identification of xanthones from the mangosteen pericarp that inhibit the growth of Ralstonia solanacearum. ACS Omega 2019, 5, 334–343. [Google Scholar] [CrossRef]
- Korni, F.M.M.; Khalil, F. Effect of ginger and its nanoparticles on growth performance, cognition capability, immunity and prevention of motile Aeromonas septicaemia in Cyprinus carpio fingerlings. Aquac. Nutr. 2017, 23, 1492–1499. [Google Scholar] [CrossRef]
- Sharif Rohani, M.; Haghighi, M.; Bazari Moghaddam, S. Study on nanoparticles of Aloe vera extract on growth performance, survival rate and body composition in Siberian sturgeon (Acipenser baerii). Iran. J. Fish. Sci. 2017, 16, 457–468. [Google Scholar]
- Hafeez, B.B.; Mustafa, A.; Fischer, J.W.; Singh, A.; Zhong, W.; Shekhani, M.O.; Meske, L.; Havighurst, T.; Kim, K.; Verma, A.K. α-Mangostin: A dietary antioxidant derived from the pericarp of Garcinia mangostana L. inhibits pancreatic tumor growth in xenograft mouse model. Antioxid. Redox Signal. 2014, 21, 682–699. [Google Scholar] [CrossRef] [PubMed]
- Zarena, A.S.; Sankar, K.U. Phenolic acids, flavonoid profile and antioxidant activity in mangosteen (Garcinia mangostana L.) pericarp. J. Food Biochem. 2012, 36, 627–633. [Google Scholar] [CrossRef]
- Salvia-Trujillo, L.; Rojas-Graü, M.A.; Soliva-Fortuny, R.; Martín-Belloso, O. Use of antimicrobial nanoemulsions as edible coatings: Impact on safety and quality attributes of fresh-cut Fuji apples. Postharvest Biol. Technol. 2015, 105, 8–16. [Google Scholar] [CrossRef]
- Abaho, I.; Masembe, C.; Akoll, P.; Jones, C.L. The use of plant extracts to control tilapia reproduction: Current status and future perspectives. J. World Aquac. Soc. 2022, 53, 593–619. [Google Scholar] [CrossRef]
- Abd El-Hamid, M.I.; Ibrahim, S.M.; Eldemery, F.; El-Mandrawy, S.A.; Metwally, A.S.; Khalifa, E.; Elnahriry, S.S.; Ibrahim, D. Dietary cinnamaldehyde nanoemulsion boosts growth and transcriptomes of antioxidant and immune related genes to fight Streptococcus agalactiae infection in Nile tilapia (Oreochromis niloticus). Fish Shellfish Immunol. 2021, 113, 96–105. [Google Scholar] [CrossRef]
- Pirarat, N.; Pinpimai, K.; Endo, M.; Katagiri, T.; Ponpornpisit, A.; Chansue, N.; Maita, M. Modulation of intestinal morphology and immunity in nile tilapia (Oreochromis niloticus) by Lactobacillus rhamnosus GG. Res. Vet. Sci. 2011, 91, e92–e97. [Google Scholar] [CrossRef]
- Pratheepa, V.; Sukumaran, N. Effect of Euphorbia hirta plant leaf extract on immunostimulant response of Aeromonas hydrophila infected Cyprinus carpio. PeerJ 2014, 2, e671. [Google Scholar] [CrossRef]
- Jenkins, J.A.; Rosell, R.; Ourth, D.D.; Coons, L.B. Electron microscopy of bactericidal effects produced by the alternative complement pathway of channel catfish. J. Aquat. Anim. Health 1991, 3, 16–22. [Google Scholar] [CrossRef]
- Kasemwattanaroj, P.; Moongkarndi, P.; Pattanapanyasat, K.; Mangmool, S.; Rodpai, E.; Samer, J.; Konlata, J.; Sukapirom, K. Immunomodulatory activities of alpha-mangostin on peripheral blood mononuclear cells. Nat. Prod. Commun. 2013, 8, 1257–1260. [Google Scholar]
- Pratiwi, Y.S.; Rahmawati, R.; Sanjaya, Y.A. Potency of mangosteen pericarp as source of antioxidant in tea to enhance immune system: A review. Nusant. Sci. Technol. Proc. 2022, 277–282. [Google Scholar] [CrossRef]
- Gregory, A.; Williamson, D.; Titball, R. Vaccine delivery using nanoparticles. Front. Cell. Infect. Microbiol. 2013, 3, 1–13. [Google Scholar] [CrossRef]
- Bachmann, M.F.; Jennings, G.T. Vaccine delivery: A matter of size, geometry, kinetics and molecular patterns. Nat. Rev. Immunol. 2010, 10, 787–796. [Google Scholar] [CrossRef]
- Zhao, L.; Seth, A.; Wibowo, N.; Zhao, C.-X.; Mitter, N.; Yu, C.; Middelberg, A.P. Nanoparticle vaccines. Vaccine 2014, 32, 327–337. [Google Scholar] [CrossRef]
- Akkaya, M.; Kwak, K.; Pierce, S.K. B cell memory: Building two walls of protection against pathogens. Nat. Rev. Immunol. 2020, 20, 229–238. [Google Scholar] [CrossRef]
- Janeway, C.A., Jr.; Travers, P.; Walport, M.; Shlomchik, M.J. B-cell activation by armed helper T cells. In Immunobiology: The Immune System in Health and Disease, 5th ed.; Garland Science: New York, NY, USA, 2001. [Google Scholar]
- Devi Sampath, P.; Vijayaraghavan, K. Cardioprotective effect of alpha-mangostin, a xanthone derivative from mangosteen on tissue defense system against isoproterenol-induced myocardial infarction in rats. J. Biochem. Mol. Toxicol. 2007, 21, 336–339. [Google Scholar] [CrossRef]
- Sail, A.M.; Mustapha, W.A.W.; Yusop, S.M.; Maskat, M.Y.; Shamsuddin, A.F. Optimisation of cinnamaldehyde-in-water nanoemulsion formulation using central composite rotatable design. Sains Malays. 2018, 47, 1999–2008. [Google Scholar] [CrossRef]
- Esmaeili, M. Blood performance: A new formula for fish growth and health. Biology 2021, 10, 1236. [Google Scholar] [CrossRef]
- Ozardali, I.; Bitiren, M.; Karakilçik, A.Z.; Zerin, M.; Aksoy, N.; Musa, D. Effects of selenium on histopathological and enzymatic changes in experimental liver injury of rats. Exp. Toxicol. Pathol. 2004, 56, 59–64. [Google Scholar] [CrossRef]
- Hamed, H.S.; Amen, R.M.; Elelemi, A.H.; Mahboub, H.H.; Elabd, H.; Abdelfattah, A.M.; Moniem, H.A.; El-Beltagy, M.A.; Alkafafy, M.; Yassin, E.M.M.; et al. Effect of dietary Moringa oleifera leaves nanoparticles on growth performance, physiological, immunological responses, and liver antioxidant biomarkers in nile tilapia (Oreochromis niloticus) against Zinc oxide nanoparticles toxicity. Fishes 2022, 7, 360. [Google Scholar] [CrossRef]
- Sukkarun, P.; Kitiyodom, S.; Yostawornkul, J.; Chaiin, P.; Yata, T.; Rodkhum, C.; Boonrungsiman, S.; Pirarat, N. Chitosan-polymer based nanovaccine as promising immersion vaccine against Aeromonas veronii challenge in red tilapia (Oreochromis sp.). Fish Shellfish Immunol. 2022, 129, 30–35. [Google Scholar] [CrossRef] [PubMed]
- Araújo, J.; Fernandes, C.; Pinto, M.; Tiritan, M.E. Chiral derivatives of xanthones with antimicrobial activity. Molecules 2019, 24, 314. [Google Scholar] [CrossRef] [PubMed]
- Zou, H.; Koh, J.-J.; Li, J.; Qiu, S.; Aung, T.T.; Lin, H.; Lakshminarayanan, R.; Dai, X.; Tang, C.; Lim, F.H. Design and synthesis of amphiphilic xanthone-based, membrane-targeting antimicrobials with improved membrane selectivity. J. Med. Chem. 2013, 56, 2359–2373. [Google Scholar] [CrossRef]
- Arabski, M.; Węgierek-Ciuk, A.; Czerwonka, G.; Lankoff, A.; Kaca, W. Effects of saponins against clinical E. coli strains and eukaryotic cell line. J. Biomed. Biotechnol. 2012, 2012, 286216. [Google Scholar] [CrossRef]

| Formulations | Average Diameter (nm) | Zeta Potential (mV) | Polydispersity Index |
|---|---|---|---|
| MSNE | 151.9 ± 1.4 | −38.3 ± 0.73 | 0.235 |
| NE | 146.4 ± 3.1 | −36.4 ± 0.80 | 0.254 |
| Formulations | Inhibition Zone (mm) | MIC (µL mL−1) | MBC (µL mL−1) |
|---|---|---|---|
| MPE | 11.67 ± 1.15 a | 62.5 | 62.5 |
| MSNE | 16.00 ± 3.00 b | 62.5 | 62.5 |
| NE | 10.67 ± 1.15 a | 62.5 | 125 |
| Enrofloxacin | 24.67 ± 1.15 c | 31.25 | 31.25 |
| DMSO (0.5%) | ND | ND | ND |
| Parameters | Control | MPE | MSNE | NE |
|---|---|---|---|---|
| Initial weight (g) | 18.26 ± 3.37 | 18.70 ± 5.42 | 18.59 ± 6.23 | 18.28 ± 4.49 |
| Final weight (g) | 34.38 ± 10.53 | 37.07 ± 17.95 | 36.81 ± 15.65 | 35.96 ± 10.15 |
| Weight gain (g fish−1) | 16.12 ± 7.49 a | 18.37 ± 12.65 b | 18.22 ± 9.77 b | 17.68 ± 6.04 b |
| Average daily gain (g fish−1 day−1) | 0.47 ± 0.25 a | 0.61 ± 0.42 b | 0.61 ± 0.33 b | 0.59 ± 0.20 b |
| Feed conversion ratio | 2.16 ± 2.55 a | 2.02 ± 2.14 a | 1.75 ± 0.62 b | 2.00 ± 0.39 a |
| Specific growth rate (% day−1) | 1.64 ± 0.62 a | 2.00 ± 0.82 b | 2.18 ± 0.46 b | 1.92 ± 0.33 ab |
| Parameters | Control | MPE | MSNE | NE |
|---|---|---|---|---|
| Blood urea nitrogen (mg dL−1) | 4.00 ± 0.00 | 5.50 ± 2.12 | 4.00 ± 0.00 | 5.00 ± 1.41 |
| Glucose (mg dL−1) | 44.00 ± 11.31 a | 51.50 ± 4.95 a | 73.50 ± 14.72 b | 50.5 ± 13.23 a |
| Alanine transferase (IU L−1) | 3.50 ± 2.12 | 5.50 ± 0.71 | 2.50 ± 0.54 | 4.50 ± 1.78 |
| Aspartate aminotransferase (IU L−1) | 160.50 ± 8.69 | 180.50 ± 7.58 | 165.50 ± 11.92 | 190.50 ± 15.26 |
| Total bilirubin (mg dL−1) | 5.70 ± 2.69 | 7.25 ± 0.35 | 4.90 ± 0.71 | 6.15 ± 5.30 |
| Direct bilirubin (mg dL−1) | 3.47 ± 1.47 | 4.44 ± 0.01 | 3.22 ± 0.28 | 3.79 ± 3.09 |
| Total cholesterol (mg dL−1) | 147.00 ± 1.41 | 144.00 ± 11.31 | 123.50 ± 6.36 | 141.50 ± 23.33 |
| Total protein (g dL−1) | 2.35 ± 0.35 a | 2.15 ± 0.07 a | 4.00 ± 0.50 b | 3.30 ± 0.28 ab |
| Albumin (g dL−1) | 1.80 ± 0.14 | 1.80 ± 0.00 | 1.65 ± 0.07 | 1.95 ± 0.35 |
| Formulations | Cumulative Mortality (%) | RPS (%) |
|---|---|---|
| Control | 76.7 ± 2.2 a | – |
| MPE | 60.0 ± 3.1 b | 21.7 ± 2.2 a |
| MSNE | 46.7 ± 1.9 c | 39.1 ± 3.1 b |
| NE | 73.3 ± 4.3 a | 4.3 ± 0.5 c |
Disclaimer/Publisher’s Note: The statements, opinions and data contained in all publications are solely those of the individual author(s) and contributor(s) and not of MDPI and/or the editor(s). MDPI and/or the editor(s) disclaim responsibility for any injury to people or property resulting from any ideas, methods, instructions or products referred to in the content. |
© 2023 by the authors. Licensee MDPI, Basel, Switzerland. This article is an open access article distributed under the terms and conditions of the Creative Commons Attribution (CC BY) license (https://creativecommons.org/licenses/by/4.0/).
Share and Cite
Yostawonkul, J.; Kamble, M.T.; Sakuna, K.; Madyod, S.; Sukkarun, P.; Medhe, S.V.; Rodkhum, C.; Pirarat, N.; Sewaka, M. Effects of Mangosteen (Garcinia mangostana) Peel Extract Loaded in Nanoemulsion on Growth Performance, Immune Response, and Disease Resistance of Nile Tilapia (Oreochromis niloticus) against Aeromonas veronii Infection. Animals 2023, 13, 1798. https://doi.org/10.3390/ani13111798
Yostawonkul J, Kamble MT, Sakuna K, Madyod S, Sukkarun P, Medhe SV, Rodkhum C, Pirarat N, Sewaka M. Effects of Mangosteen (Garcinia mangostana) Peel Extract Loaded in Nanoemulsion on Growth Performance, Immune Response, and Disease Resistance of Nile Tilapia (Oreochromis niloticus) against Aeromonas veronii Infection. Animals. 2023; 13(11):1798. https://doi.org/10.3390/ani13111798
Chicago/Turabian StyleYostawonkul, Jakarwan, Manoj Tukaram Kamble, Kitikarn Sakuna, Sulaiman Madyod, Pimwarang Sukkarun, Seema Vijay Medhe, Channarong Rodkhum, Nopadon Pirarat, and Mariya Sewaka. 2023. "Effects of Mangosteen (Garcinia mangostana) Peel Extract Loaded in Nanoemulsion on Growth Performance, Immune Response, and Disease Resistance of Nile Tilapia (Oreochromis niloticus) against Aeromonas veronii Infection" Animals 13, no. 11: 1798. https://doi.org/10.3390/ani13111798
APA StyleYostawonkul, J., Kamble, M. T., Sakuna, K., Madyod, S., Sukkarun, P., Medhe, S. V., Rodkhum, C., Pirarat, N., & Sewaka, M. (2023). Effects of Mangosteen (Garcinia mangostana) Peel Extract Loaded in Nanoemulsion on Growth Performance, Immune Response, and Disease Resistance of Nile Tilapia (Oreochromis niloticus) against Aeromonas veronii Infection. Animals, 13(11), 1798. https://doi.org/10.3390/ani13111798

